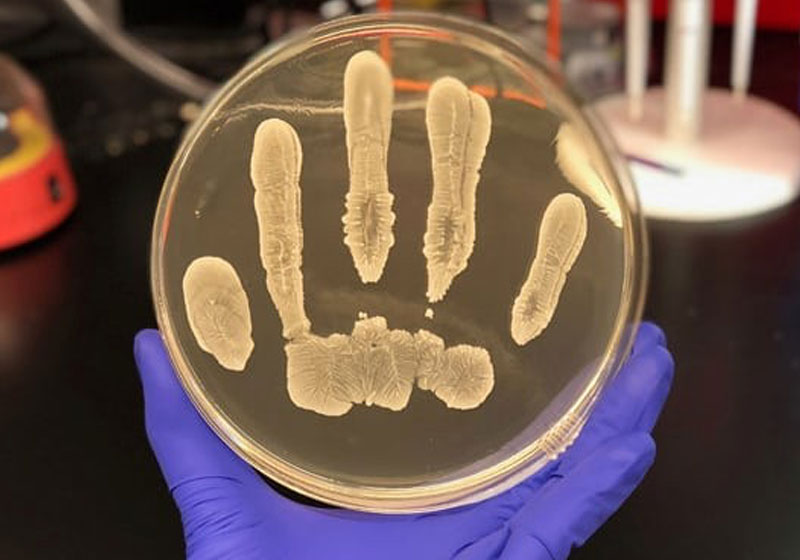
Staphylococcus epidermidis Foto: UC San Diego Health

Micróbios do próprio corpo reduzem risco de câncer de pele
Micróbios que vivem no nosso corpo ajudam a nos proteger contra o câncer de pele.
É a linhagem do Staphylococcus epidermidis, bactéria comum na pele humana que produz uma substância capaz de ajudar a prevenir a doença.
Apesar de a S. epidermidis ser comum, cientistas norte-americanos acreditam que apenas 20% da população saudável carregam a linhagem da bactéria que produz a poderosa substância.
“A presença dessa espécie pode promover proteção natural, ou pode ser usada terapeuticamente para inibir o crescimento de várias formas de câncer,” afirma Richard Gallo, um dos autores da pesquisa publicada na Science Advances.
O estudo
Em pesquisas anteriores já era notado que a bactéria aparecia principalmente em peles saudáveis e tinha a capacidade de matar micróbios nocivos, como os que causam a amigdalite.
A equipe de cientistas norte-americanos explorou a fundo as funções da 6-N-hydroxyaminopurine (6-HAP), substância produzida pela bactéria e responsável por esses efeitos.
Os pesquisadores testaram como a substância agia sobre tumores em dois grupos de ratos: um que tinha recebido uma dose de 6-HAP e outra que não.
Os tumores do grupo com 6-HAP apresentaram tumores 60% menores. Isso acontece porque a substância previne o crescimento e a multiplicação de uma série de tipos de tumores.
Além disso, os cientistas observaram que houve uma grande redução de tumores de pele
pré-malignos nos animais.
Com informações da Revista Galileu

Stanford anuncia cura de diabetes tipo 1 em ratos com novo tratamento; sem efeitos colaterais
Justiça nega direito à polilaminina, mas idoso consegue na Anvisa e recebe a dose a tempo; vídeo
Jogador de vôlei que ficou tetraplégico volta a mexer o braço após a polilaminina; vídeo
Cientistas conseguem reverter doença renal crônica: restauraram funções dos rins pela 1ª vez
Semaglutida pode ser eficaz contra aumento da gordura no fígado, diz especialista
Antonio Banderas vai bancar pesquisa de câncer de pâncreas do dr. Mariano Barbacid
Alok doa 9 toneladas de suprimentos para vítimas das chuvas em Minas Gerais
Sai ranking dos carros mais econômicos e menos poluentes do Brasil
Bombeiro retira jiboia do teto da casa de uma família sem machucar o animal; assista
Presidente do Sebrae apoia fim da escala 6×1; Vai gerar 4.5 milhões de novos empregos, diz estudo
Cachorro avisa tutora sobre câncer de mama e salva a vida dela: “não estaria aqui”
Professora ganha presentes inusitados de alunos idosos do EJA do interior: gratidão; vídeo